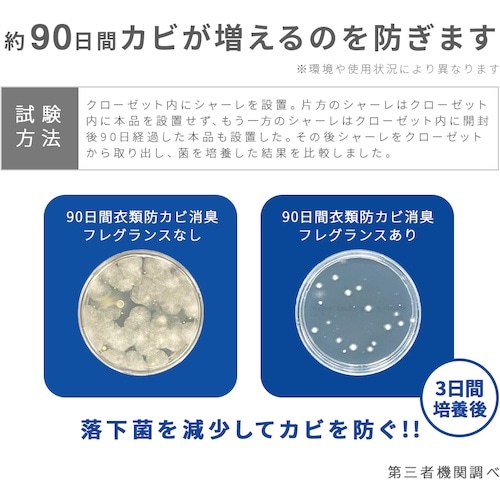
アイメディア 90日間衣類防カビ消臭フレグランス

消臭剤/芳香剤(その他)の売れ筋ランキング
- ¥460(税込) (税込)
- ¥1,035(税込) (税込)
- ¥850(税込) (税込)
- ¥930(税込) (税込)
- ¥664(税込) (税込)
- ¥850(税込) (税込)
- ¥664(税込) (税込)
商品の特徴 |
24時間ほのかな香り、クローゼット内をカビから守って防カビ・消臭。※すべての臭い、カビに効果があるわけではありませんクローゼットや押し入れにポンと置くだけの簡単設置。 |
|---|---|
商品仕様 |
|
メーカー情報 |
|
カタログ掲載ページ |
-/- |
| 注意事項 | ※【返品に関するご注意】この商品は直送品のため、お客様のご都合による返品はお受けできません。 |
|---|